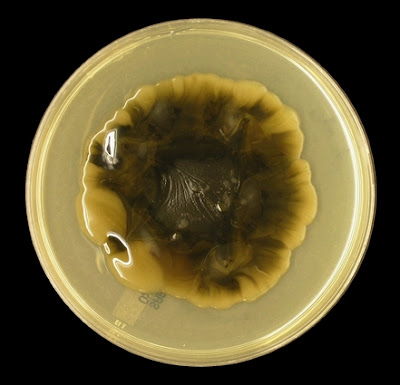

Exophiala dermatitidis (Wangiella dermatitidis)Fungus
Note: The current name for this fungus is Exophiala dermatitidis, changed fairly recently from Wangiella dermatitidis & Phialophora dermatiditis earlier still). Molecular studies have shown it is related to Exophilia as a separate species and does not warrant its own genus (Wangiella) containing the single species (dermatitidis). Originally it was thought this organism differed from Exophialaby its ability to produce phialides from which the conidia are produced.
Ecology: Exophiala dermatitidis is a cosmopolitan (found almost everywhere) saprobe (lives of off dying/decomposing material). It can be isolated from soil, decaying wood, plants and from water.
Macroscopic Morphology: Shown here on Sabouraud Dextrose Agar (SAB or SDA) incubated at 30oC, colonies are black to olive-black, often with greyish to brownish colours showing through, particularly at the periphery where the growth is younger. The brownish pigment may diffuse into the surrounding media. It somewhat resembles molasses or perhaps dirty old motor oil. Reverse is much the same with a dark grey to iron-black colour. Growth is slow to moderate as the organism visible growth appears quickly but the colony is rather slow to expand and mature. A distinguishing feature is the sticky, wet, mucoid growth this fungus initially produces. A slimy string can be produced between the colony and an inoculating loop attempting to pick it up. Some filamentous growth may occur on prolonged incubation or after several subcultures. One source suggests that SAB media may encourage this.
Hints: I didn’t have much luck with adhesive tape preparations with this ‘goo-y’ growth. It’s like trying to pick up a drop of motor oil with scotch tape! Initially the fungus produced only yeast cells however some filamentous growth was finally visible at the center of the colony (oldest growth) after prolonged incubation (1 month). Other sources suggest the velvety or filamentous growth may be first seen at the periphery. The plate photo below is of a subculture incubated for about one month at 30oC. The majority of the photos shown below were taken of Exophiala dermatitidisgrowing on a slide culture, harvested after about 10 days of incubation at 30oC. I found this to be the most effective technique for viewing this organism. Hyphae are sparse but can be found growing out of the mass of yeast cells.
Exophiala dermatitidis on SAB after about 1 Month at 30oC
This organism grows fairly slowly and produces a wet, sticky, rather black looking colony. Reverse (not pictured) is much the same. Hyphal growth may appear after prolonged incubation and perhaps is encouraged by repeated subculture. Note the center of the growth appears more dry. The colony above was so shiny and glistening from the wet appearance that white bright spots on the left side of the colony are simply reflected light. (Nikon)
Microscopic Morphology: Yeast cells are abundant with early growth appearing hyaline (clear) but acquire an olive colouration quickly. The sparse hyphae are septate and also have a pale olivaceous appearance in a wet mount. Conidiophores are poorly differentiated, often indistinguishable from the vegetative hyphae. Phialides are also poorly differentiated and are generally ellipsoidal in shape. Exophiala dermatitidis may somewhat resemble Phialophorahowever they do not produce the collarettes that are present on Phialophora. The phialides can be intercalary (produced along the hyphae) or terminal (at the end). Conidia are smooth, one-celled, subglobose to ellipsoidal (2.5 - 4 µm by 2 – 3 µm). Somewhat spherical phialides may also be present producing phialoconidia of about the same size. The conidia generally accumulate around the apex (tip) of the phialide.
Exophiala dermatitidis - Not much detail here but this photo shows the yeast cells mass at the bottom of the photo from which hyphae have grown outwards. This was taken from the growth adhering to a microscope cover-slip taken from a slide culture after 10 days incubation at 30oC.
(LPCB DMD-108 X40)
Exophiala dermatitidis - as above (LPCB DMD-108 X250)
Just to give you an initial view of the colony before cranking up the magnification.
Exophiala dermatitidis - at higher magnification the typical structures now appear. At the bottom of the photo you can see the conidiogenous cells with conidia that have accumulated around their tip. The cells at the top of the photo are out of the plane of focus but show much the same.
(LPCB DMD-108 X400)
Exophiala dermatitidis - Branched hyphae visible from which the poorly differentiated conidiogenous structures extend. Oblong phialides can be seen and numerous oval conidia can be seen, particularly gathered around the somewhat obscured phialides on the left of the photo.
(LPCB, DMD-108 X1000)
Exophiala dermatitidis- Elongated ovoid conidia seen gathered at the tip of one hyphal element and along it's length. Inset & arrows: show the attachment point along the hyphae.
(LPCB, DMD-108 X1000)
Exophiala dermatitidis - Shows hyphae which have poorly differentiated conidiogenous cells at the tip (ie. they don't look much different from the hyphae itself. The phailides are the terminal cells from which the conidia are produced. Again the conida can be seen accumulating around the tip of the cell from which they were produced. Production of conidia can be seen at the end (terminal phialides) and along the length (intercalarly phialides).
Exophiala dermatitidis- Hyphae seen with oval or 'vase' shaped intercalary phialides at various locations along it's length. Again the far end of the hyphae shows poorly differentiated conidiogenous cells with a terminal phialide. Conidia accumulate as clusters around both.
(LPCB, DMD-108 X1000)
Exophiala dermatitidis- Another view shows hyphae with conidiogenous cells branching off and the somewhat oval of 'vase' shaped phialides at their apex (tip). Elongated, oval conidia have accumulated around the tip.
(LPCB, DMD-108 X1000)
Exophiala dermatitidis - Yeast cell mass at right of photo with single hyphae in center showing accumulation of oval conidia round the tip and along it's length.
Exophiala dermatitidis - Septa in hyphae are visible. Phialide extending from hyphae is seen with conidia accumulated around the apex.
(LPCB, DMD-108 X1000+10*)
Exophiala dermatitidis - Another view of a branch from a septate hyphae which can be seen differentiating towards the end where the conidia are accumulating (ie. the cells are taper inwards where their are septa - at least two are visible)
(LPCB, DMD-108 X1000)
Exophiala dermatitidis - Mass of yeast cells seen at right of photo with two phialides seen extending from hyphae near center and the conidia they have produced.
(LPCB, DMD-108 X1000)
Exophiala dermatitidis - Hyphae with phialides showing accumulated oval conidia around their tip.
(LPCB, DMD-108 X1000+10*)
Exophiala dermatitidis - Another example as in the previous photo. Compare this to Phialophora verrucosa. No collerette is produced byExophiala dermatitidis but can be found on Phialophora.
Exophiala dermatitidis - Yeast cells on left with hyphae extending outwards. One phialides along length and an other(s) at end where conidia have accumulated at tip.
(LPCB, DMD-108 X1000+10*)
Exophiala dermatitidis - Another photo, this with micron bar for scale. Both Terminal (T) and intercalary (I) phialides are seen with the characteristic accumulation of conidia.
(LPCB, DMD-108 X1000)
Exophiala dermatitidis - Intercalary phialides producing conidia.
(LPCB DMD-108 X1000)
Exophiala dermatitidis - Another example (I hate textbooks with only one small B&W print of the fungus in question - you really can't get a feel of the organism)
A single hyphae extending from mass of cells on right (look like both yeast cells and conidia) with conidia accumulating around tip and along side of hyphae.
Exophiala dermatitidis - Back to the beginning. Just a photo of a wet-mount from a 48 hour culture incubated at 40oC. Only a few cells are beginning to develop the dark colour.
(Saline, DMD-108 X1000*)
Differentiation: Exophiala dermatitidis does not assimilate potassium nitrate and grows at 40oC which differentiates it from the related Exophiala jeanselmei. While both Exophiala dermatitidisand Phialophora verrucosa produces black colonies, the wet, sticky texture of E.dermatitidis cannot be mistaken for the dry, velvety P.verrucosa. As mentioned earlier, the phialides of E.dermatitidis do not have collarettes as P.verrucosa does.
Pathology: Has been implicated in subcutaneous and disseminated phaeohyphomycosis, particularly after traumatic implantation. E.dermatitidishas been isolated from pulmonary specimens and may occasionally cause pneumonia. Intervenious and catheter devices are thought to be a possible portal of entry. Cystic fibrosis patients may be at increased risk of acquiring an infection with E.dermatitidis. The organism also shows increased neurotropism (preferential infection of the central nervous system).
* The DMD-108 refers to the Leica Digital Microimaging Device microscope. This microscope is capable of adding X10 digital magnification to any objective magnification. A +10 after any stated magnification indicates this feature was used. Read more about this microscope here.
Return to Top (Most Recent Posts)